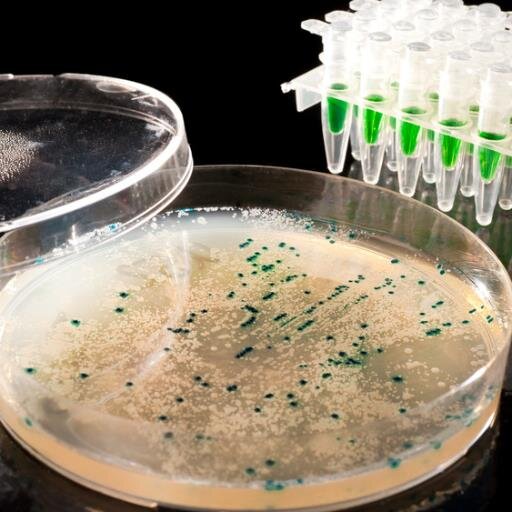

Polaris Research Solutions @PolarisInform
#foodsafety #FSMA #foodscience #foodlabeling #nutrition #clinicalresearch #health #USDA #FDA #CFIA #foodregulation United States Joined October 2015-
Tweets284
-
Followers75
-
Following179
-
Likes39
How hiring the wrong medical “expert” derailed US pandemic response arstechnica.com/?post_type=pos…
@USATODAY Really @StateFarm thanks for clarifying that lying is ok with your company. Aaron could have simply said I am not vaccinated but will follow NFL rules. Then I could see you standing by him. Now I get it…you support lying. Is that the same for your rates?
@USATODAY @StateFarm do you encourage your drivers to drink & drive, not wear a seatbelt?What about peoples life insurance policies? No consequences for the rich white & famous! Gosh, we can’t do that. 😡
@USATODAY does @StateFarm support him deliberately misleading the public? not a great sign from them...
German magazine Der Spiegel names Trump 'Loser of the Year' thehill.com/homenews/media…
@WotanTX @PlanetFitness YAAASSS! @PlanetFitness in Peoria Phase 4 ...no employees wearing masks..not enforcing members...so we can just keep spreading pandemic! What was your email said? Oh yea! It’s safe here we are following all CDC/dept health regulations! U LIED..SO I SAY BYE BYE
Wayne County Republican who asked to ‘rescind’ her vote certifying election results says Trump called her washingtonpost.com/nation/2020/11…
"Why would you send a lie like that to your followers?" Guthrie asked. 👏👏 businessinsider.com/savannah-guthr…
Sully Sullenberger stepped up in a critical moment and now he asks that we do the same. That we do what’s needed and what’s critical to save our nation from Trump's chaotic destruction. We're proud to have co-sponsored this with @ProjectLincoln. #SullyVsTrump #VoteHimOut
The President is disgusting and racist, but it’s the people in the audience who break my heart. Cheering bigotry. Shamelessly. Whew. That’s a tough thing to swallow. Gotta tell you.
The President is disgusting and racist, but it’s the people in the audience who break my heart. Cheering bigotry. Shamelessly. Whew. That’s a tough thing to swallow. Gotta tell you.
Let’s make him famous.
My Dad was not a nobody.
Firstly, this is my country & I am a member of the House that impeached you. Secondly, I fled civil war when I was 8. An 8-year-old doesn’t run a country even though you run our country like one.
Firstly, this is my country & I am a member of the House that impeached you. Secondly, I fled civil war when I was 8. An 8-year-old doesn’t run a country even though you run our country like one.
Donald Trump should stop lying, and quit playing politics with our lives; his Lie House press secretary should resign #ByeKaleigh
Donald Trump should stop lying, and quit playing politics with our lives; his Lie House press secretary should resign #ByeKaleigh
Arsenic as a Food Safety Hazard – 5 Facts to Consider foodsafety.merieuxnutrisciences.com/2020/09/01/ars… #FDA #foodsafety
Proposition 65 – Will the New California Warning Requirements Impact Your Business? #foodlabeling foodsafety.merieuxnutrisciences.com/2020/07/28/pro…
#FDA Unveils a New Era of Smarter Food Safety – 4 Core Elements to Watch #FSMA #foodsafety foodsafety.merieuxnutrisciences.com/2020/07/21/fda…
German state laboratories find mineral oil in baby milk foodwatch.org/en/news/2020/g…

Quality Assurance @QAMagazine
2K Followers 529 Following Quality Assurance & Food Safety Magazine, a GIE Media publication. Follow for industry news, info and updates.
Sorsat @SorsatY4oArm
0 Followers 662 Following
FMI @FMI_ORG
13K Followers 3K Following FMI works with and on behalf of the entire industry to advance a safer, healthier & more efficient consumer food supply.
TDNet Info-Leaders Po... @LibraryTDNet
335 Followers 4K Following Looking to provide the Information & Library community with content from our Info-Leaders Podcast and interesting updates on TDNet library solutions.
Yvonne Luna Bueno @YvonneLunaBuen1
160 Followers 1K Following Make A https://t.co/DaxE7Un3Le Awaiting Court for DPS Officer 2010/2011 Case & 2015 arrest https://t.co/hvmdN3xrBZ Person, Place & Thing of Nature; based on a True
The Acheson Group @TheAchesonGroup
704 Followers 415 Following A strategic consulting firm for food and beverage companies and those providing technical support to the food industry focusing on strategic risk management
Michael B Potter @MPotter415
707 Followers 5K Following FNDR @MbpNetworks EVP @AdentroMktg - Passionate startup builder, problem solver creator, connector, campaigner 4 social impact focused startups + founders
Faisal Shah @FaisalBIOTECH
7 Followers 61 Following Pursuing Ph.D. (Doctorate)in Food Science and Technology from IFST,CAAS, Beijing, China. Open for research opportunities in food science area.
PathoGenator @PathoGenator
41 Followers 581 Following Terminator of pathogens transmitted by deadly viral microorganisms, mosquitoes, and ticks.
Food Safety Insider @food_safety_us
91 Followers 200 Following Subscribe to Food Safety Insider for up to date food safety news you can use. #foodtraceability #foodsafety #sqf #haccp #pcqi #foodrecalls #foodpoisoning #gfsi
Augustine Louise @AugustineLouise
27 Followers 284 Following
Optisolve @OptiSolve
330 Followers 1K Following Optisolve provides a proactive and preventative full-service offering to enhance and advance cleaning procedures to reduce the spread of harmful pathogens.
Moodbytes @Moodbytes_io
36 Followers 76 Following Moodbytes is a company dedicated to innovation in the culinary world, Create a more sustainable, smart and shared future gastronomy.
Rick Gilmore @rickgilmore_
1K Followers 3K Following CEO, GIC Group; Chairman, Global Food Safety Forum, Trustee Nutrien, Swiss investment Board member,author, media commentator,chairman of Rosenthal Fellowship
Paradise™️ @ParadiseSpreads
141 Followers 729 Following 🥄 World’s 1st Pea Protein Spread Allergy Friendly. 👩🏽🍳Female founded: @EmilyDEdwards3 @Amazon @Faire @Thrive + moreSyed Khaja Arifuddin,... @ariffood
748 Followers 5K Following Ph.D.( Food Tech.), Lead Instructor Training for FSPCA ; Food Laws & Regulations, Sustainable Development & Climate Change . RTs are not endorsement
Seawind Foods @SeawindFoods
793 Followers 3K Following We're a supplier of naturally dehydrated fruits, veggies, & spices to food processors, retailers, and consumer brands.🥦🥕 Read our blog: https://t.co/dFeQTf7Uzd
Falsum Consulting @FalsumConsult
466 Followers 4K Following Falsum is a leading Global Trade & Customs consultancy. Unique perspective. Fresh insight.
Alimenti Food Science... @alimenti_fs
3K Followers 4K Following Working with food & drink business owners to take away the stress of food safety.Allergens, HACCP & Microbiology. Founder of #UKFoodHour call on 07904 384833.
Ramiro Rojas Mondrag�... @RamiroRojasMon1
883 Followers 5K Following
Anna Colangelo @colangelo_anna
6 Followers 79 Following
C&C Professionals @HappyHACCP
361 Followers 1K Following Food Safety Consultant to the #Foodies dedicated to training and supporting #ArtisanFood #SmallerProducers. Passionate for #food and #safety.
Olowolagba AkinStawo @AkinStawo
148 Followers 576 Following Hygiene, Quality, Food Safety & Public health Professional. MSc Public Health & BSc Microbiology. Trained international Speaker. Advocate of Safe Food.
Solus Scientific @SolusScientific
116 Followers 201 Following Solus Scientific manufactures highly efficient testing systems for the food safety industry.
FoodSafetyChef, Inc. @FoodSafetyChef
2K Followers 2K Following Food Safety and Culinary Arts Instructor. Food Safety Manager, Handler and, Responsible Vendor Training. Facebook: Food Safety Chef
3TS @3T78975819
112 Followers 3K Following
Allan Wick @alwick
267 Followers 1K Following Al is a Software Craftsman with over 20 years of experience developing many types of software products as well as managing the development.
Presage Analytics #Pr... @PresageAnalytic
1K Followers 5K Following Hi! Helping #foodsafety professionals digitize processes, trace data, prevent errors, and realize time savings through your favorite, flexible software system.
Food Safety 2019 Cong... @Food_Safety2018
363 Followers 1K Following #FoodSafetyCongress presents the 2nd International Conference on #FoodSafety and #Hygiene at London on March 2019 [email protected]
Healthy Balance Holis... @tarakantle
960 Followers 3K Following Healthy Balance Health Group brings world-renowned, leading-edge health research & practices to Newfoundland & Labrador. Come visit us today; our kettle is on!
Kate Mal @ KSM Food S... @kmalvetti
397 Followers 2K Following Owner at KSM Food Safety Consulting - Food Safety Made Simple. FSPCA Lead Instructor for PCQI and FSVP; Food Safety Consultant, Compliance Specialist, & Trainer
Gentle Processing™ @SaferFood_GP
29 Followers 157 Following Gentle Processing™ is a green technology on the cutting edge of food & ingredient manufacturing. "Nutrition the way Nature Intended"
KML Laboratories @KML_Labs
43 Followers 320 Following KML Laboratories is an innovative microbiology testing service, providing honorable test results with the quickest turnaround time in the industry.
Beverages MDPI @Beverages_MDPI
658 Followers 2K Following Beverages (ISSN 2306-5710) is an international, peer-reviewed open access journal on beverage research and development published online quarterly by MDPI.
westchesterfoodsafety @servsafenynow
444 Followers 2K Following Food Managers ServSafe certification
Food Safety Quality A... @fsqaresources
839 Followers 2K Following Resources for Food Safety & Quality Assurance professionals. #foodsafety #foodtech #foodpoisoning #safefood #HACCP #foodsafetyjobs #SQF #BRC #FSMA #IAFP #IFT
ATIGAN Komlan Dovén�... @ATIGAND
293 Followers 3K Following Food Scientist/Slow Food Youth Network-Togo Leader/Active member of the Young African Leaders Initiative/Slow Food Youth Network Africa board member
IFRI @IFRI60687911
1 Followers 11 Following
Dr Tahir Sheikh @DrTahirSheikh2
2K Followers 4K Following veterinary Expert Biotechnology & Pharmaceutical
Mauricio Rousselon - ... @FWSMEX
638 Followers 1K Following Q-Food and Water Safety Mexico™ expert consultants in Mexican Food Safety. Lead instructors of FSMA's IAVA, PCQIHF, FSVP & the Produce Rule, plus Seafood HACCP.
MXNS México @MXNSMexico
221 Followers 104 Following Mérieux NutriSciences es un laboratorio de análisis que ofrece servicios de inocuidad alimentaria, medio ambiente, agroquímicos, pharma, y cuidado personal.
AFDO @afdonews
737 Followers 685 Following Association of Food and Drug Officials: Promoting Public Health, Fostering Uniformity, and Establishing Partnerships since 1896
ChemLinked @ChemLinked
729 Followers 155 Following Leading provider of global regulatory information and market intelligence across #Food, #Cosmetic, #Chemical & #Agrochemical industries. [email protected]
Bryant Christie Inc. @bryantchristie
336 Followers 676 Following BCI helps companies and organizations open, access, and expand international markets. We focus on the agricultural, food, and beverage sectors. EOE
EDF Safer Chemicals @EDFChemicals
4K Followers 1K Following We've moved! Follow us at @EDFhealth to stay in the loop on safer chemicals & everything else we’re doing to support healthy communities.
Safer States @saferstates
4K Followers 1K Following An alliance of diverse environmental health organizations & coalitions from across the nation committed to building a healthier world. 🌎 💚
DuckDuckGo @DuckDuckGo
2.7M Followers 4 Following Independent online protection company. Get our mobile & desktop browser with protections built-in, including our search engine that doesn't track you.
Food Safety Quality A... @fsqaresources
839 Followers 2K Following Resources for Food Safety & Quality Assurance professionals. #foodsafety #foodtech #foodpoisoning #safefood #HACCP #foodsafetyjobs #SQF #BRC #FSMA #IAFP #IFT
ProQuest, from Clariv... @ProQuest
27K Followers 3K Following ProQuest, from Clarivate, is committed to empowering researchers and librarians around the world.
FoodSafety.gov @foodsafetygov
95K Followers 203 Following #FoodSafety news, tips, and recalls from https://t.co/0yrx809MoV, an official website of the United States government. Follows are not endorsements.
USDA Food and Nutriti... @USDA_FNS
120K Followers 865 Following Serving our nation’s most vulnerable, connecting farmers to communities, and promoting work over welfare, while respecting American taxpayer generosity.
IFST @ifstnews
8K Followers 1K Following Inspiring excellence and trust in food. The UK’s leading professional body for all involved in food science & technology. RT's are not endorsements.
EBSCO @EBSCO
21K Followers 2K Following EBSCO is a leading global provider of online research content & AI-enabled search technologies for libraries, healthcare, corporations, and government agencies.
IFIS Publishing @IFIS_foodinfo
3K Followers 3K Following Great research needs sound science. Research better with FSTA & IFIS Collections, our food information discovery tools for academia, industry & government
UConn Rudd Center @UConnRuddCenter
15K Followers 1K Following Devoted to promoting solutions to #foodinsecurity, #schoolmeals, #foodmarketing, and #weightbias through research and policy.
EWG @ewg
62K Followers 336 Following EWG is a nonprofit, non-partisan org working to empower people to live healthier lives in a healthier environment. Posts about our work, news & the news media.
Eurofins US Food, Fee... @eurofinsusfood
3K Followers 98 Following With over 200 laboratories globally, Eurofins boasts an unrivaled range of testing capabilities for the food, feed, plant health, grain and seed industries.
Meat Institute @MeatInstitute
12K Followers 2K Following The Meat Institute supports the businesses processing meat and their supplier partners that sustainably nourish families around the world.
FoodTrack Inc. @FoodTrackInc_
79 Followers 350 Following Food safety and recall information delivered in real-time, 24/7/365
UCLA Food Law @UCLAFoodLaw
2K Followers 749 Following National think tank for improving the modern food system @UCLA_Law
FMI @FMI_ORG
13K Followers 3K Following FMI works with and on behalf of the entire industry to advance a safer, healthier & more efficient consumer food supply.
Lumar Food Safety @LumarFoodSafety
848 Followers 2K Following SQF Approved Training Centre, BRCGS and SQF approved: Trainer, Consultant, Auditor. Helping the Food Supply Chain. Agents, Brokers, Distributors, manufacturers
SGS @SGS_SA
16K Followers 258 Following When you need to be sure We’re the world’s leading Testing, Inspection and Certification company.
Intertek @Intertek
10K Followers 243 Following Intertek is a leading Total Quality Assurance provider to a wide range of industries through our network of 1,000+ labs and offices in more than 100 countries.
Wiley Food Science @wileyfoodsci
8K Followers 94 Following We publish books & research in food science, agriculture, dairy foods, ingredients and food packaging.
Steritech @Steritech
860 Followers 285 Following Steritech is the leading provider of specialized brand protection services in North America.
Foodsafety4u @foodsafety4u
995 Followers 3K Following I eat this stuff up! Food Safety expert who Tweets about food safety, food policy and other issues in the food industry.
NSF International - F... @foodsafetybites
3K Followers 107 Following NSF International is the most widely known and respected food assurance brand, protecting consumers and enhancing business throughout global food supply chains.
EHA Consulting Group @EHAConsultingGp
323 Followers 442 Following EHA Consulting Group has 30 years of experience in the fields of environmental and public health. Tweets are on #foodsafety, #recalls, & #outbreaks.
Appen Jobs @lifeatappen
7K Followers 990 Following Follow us at @AppenGlobal for the latest remote work news and jobs.
MyFoodTox @foodtoxbabe
76 Followers 131 Following Food toxicology. Food safety. Food microbiology. Molecular biology. Chemistry. Food Science.
Strategic & Competiti... @SCIP
3K Followers 460 Following The global non-profit advancing the practice of ethical CI through training, best practices & strong peer connections
FSMA GURU @FSMA_GURU
112 Followers 150 Following Helping to bridge the gaps with #FSMA for a safer global food supply chain.
FARE | Food Allergy R... @FoodAllergy
23K Followers 993 Following FARE is the largest US nonprofit organization dedicated to driving research and a cure for the more then 33 million people in the US with food allergies
joan murphy @Joan_FoodChem
339 Followers 822 Following Senior Editor on food and ag policy for IEG Policy (formerly Food Chemical News). Hockey mom and Washington Capitals fan.
Food Poisoning Bullet... @FPBulletin
1K Followers 842 Following Food Poisoning Bulletin is your primary Google news site for breaking food recalls, outbreaks, and everything you need to know about food safety.
Cardinal Health @cardinalhealth
18K Followers 1K Following Cardinal Health is a distributor of pharmaceuticals, medical & lab products. A global manufacturer with operations in 30 countries, with 48,000 employees.
Medline @Medline
8K Followers 2K Following Medline is the largest provider of medical-surgical products and supply chain solutions serving all points of care.
National Cancer Insti... @theNCI
224K Followers 4K Following The U.S. government’s agency for cancer research. Part of @NIH. Engagement ≠ endorsement. Questions about cancer? Reach us here: https://t.co/yQAi9x4Obg
Biomapas @Biomapas_
174 Followers 278 Following Full solution provider of #ClinicalResearch, #RegulatoryAffairs, #Pharmacovigilance, #MedicalInformation services. Terms of use: https://t.co/dXa7GpQWC0
Carolina Phase I @CarolinaPhase1
69 Followers 150 Following Carolina Phase I Clinical Research is part of the Wake Research family of research facilities providing state of the art Phase I clinical research.
mvclinical @mvclinical
99 Followers 641 Following Mount Vernon Clinical Research seeks volunteers for studies who’ll receive study-related medical care and medication at no cost. Compensation is provided.
John Spink @FoodFraud
2K Followers 174 Following Dr. John Spink is Director of the Food Fraud Initiative and an Assistant Professor at Michigan State University, see https://t.co/p56sCR1pgC
Cindy @ckoschet
237 Followers 204 Following Strategic Project Manager @ Food Science and Nutrition Department (FDSN) @ IllinoisTech
MSU Online Food Safet... @MSUFoodSafety
2K Followers 228 Following Official account of the Michigan State University Online Masters in Food Safety Program. Who will keep food safe? Spartans Will.
FoodLabAlliance @AllFoodLab
339 Followers 23 Following We're all about promoting food safety and the quality of food laboratory testing.